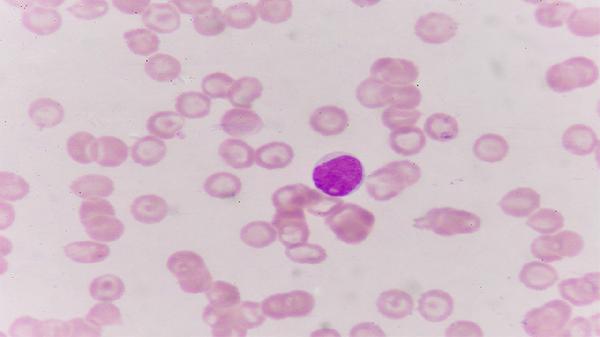
妊娠滋养细胞疾病有什么症状

妊娠滋养细胞疾病有什么症状
妊娠滋养细胞疾病可能出现阴道不规则出血、子宫异常增大、妊娠剧吐等症状。妊娠滋养细胞疾病主要包括葡萄胎、侵蚀性葡萄胎、绒毛膜癌等,症状表现与疾病类型有关,常见症状有阴道流血、腹痛、贫血、甲状腺功能亢进等。

1、阴道不规则出血
阴道不规则出血是妊娠滋养细胞疾病最常见的症状,出血量可多可少,颜色多为暗红色或鲜红色。葡萄胎患者常在停经后出现阴道流血,侵蚀性葡萄胎和绒毛膜癌患者可能在葡萄胎清除后或流产后出现持续性阴道流血。阴道不规则出血可能与滋养细胞异常增生、侵蚀血管等因素有关,通常表现为出血时间延长、出血量异常等症状。患者可遵医嘱使用氨甲环酸片、酚磺乙胺注射液、肾上腺色腙片等药物止血。
2、子宫异常增大
子宫异常增大是妊娠滋养细胞疾病的典型症状之一,葡萄胎患者的子宫往往大于停经月份,而侵蚀性葡萄胎和绒毛膜癌患者的子宫可能不均匀增大或复旧不全。子宫异常增大可能与滋养细胞过度增生、宫腔内积血等因素有关,通常表现为子宫质地柔软、子宫形态不规则等症状。患者需通过超声检查明确诊断,必要时需进行清宫术或子宫切除术。
3、妊娠剧吐
妊娠剧吐在妊娠滋养细胞疾病中较为常见,尤其是完全性葡萄胎患者,呕吐症状往往比正常妊娠更为严重。妊娠剧吐可能与体内人绒毛膜促性腺激素水平异常升高有关,通常表现为频繁呕吐、无法进食、体重下降等症状。患者可遵医嘱使用维生素B6片、甲氧氯普胺片、盐酸昂丹司琼注射液等药物缓解症状,同时需注意补液纠正水电解质紊乱。

4、腹痛
腹痛可能出现在部分妊娠滋养细胞疾病患者中,疼痛程度从隐痛到剧烈疼痛不等。腹痛可能与子宫快速增大、滋养细胞浸润子宫肌层或穿透子宫壁等因素有关,通常表现为下腹持续性或阵发性疼痛等症状。侵蚀性葡萄胎和绒毛膜癌患者若出现突发剧烈腹痛,需警惕子宫穿孔可能。患者可遵医嘱使用布洛芬缓释胶囊、对乙酰氨基酚片、盐酸哌替啶注射液等药物止痛。
5、甲状腺功能亢进
甲状腺功能亢进可见于部分妊娠滋养细胞疾病患者,尤其是人绒毛膜促性腺激素水平显著升高者。甲状腺功能亢进可能与人绒毛膜促性腺激素的甲状腺刺激作用有关,通常表现为心悸、多汗、手抖、体重下降等症状。患者可遵医嘱使用丙硫氧嘧啶片、甲巯咪唑片、普萘洛尔片等药物控制症状,多数患者在妊娠滋养细胞疾病治愈后甲状腺功能可恢复正常。
妊娠滋养细胞疾病患者应注意休息,避免剧烈运动和重体力劳动,保持外阴清洁以防感染。饮食上应保证营养均衡,多摄入富含优质蛋白和铁的食物如瘦肉、鸡蛋、菠菜等,有助于改善贫血症状。患者需严格遵医嘱定期复查人绒毛膜促性腺激素水平,监测病情变化,如有异常出血、腹痛加剧等情况应及时就医。心理上应保持乐观心态,积极配合治疗,家属应给予充分的理解和支持。